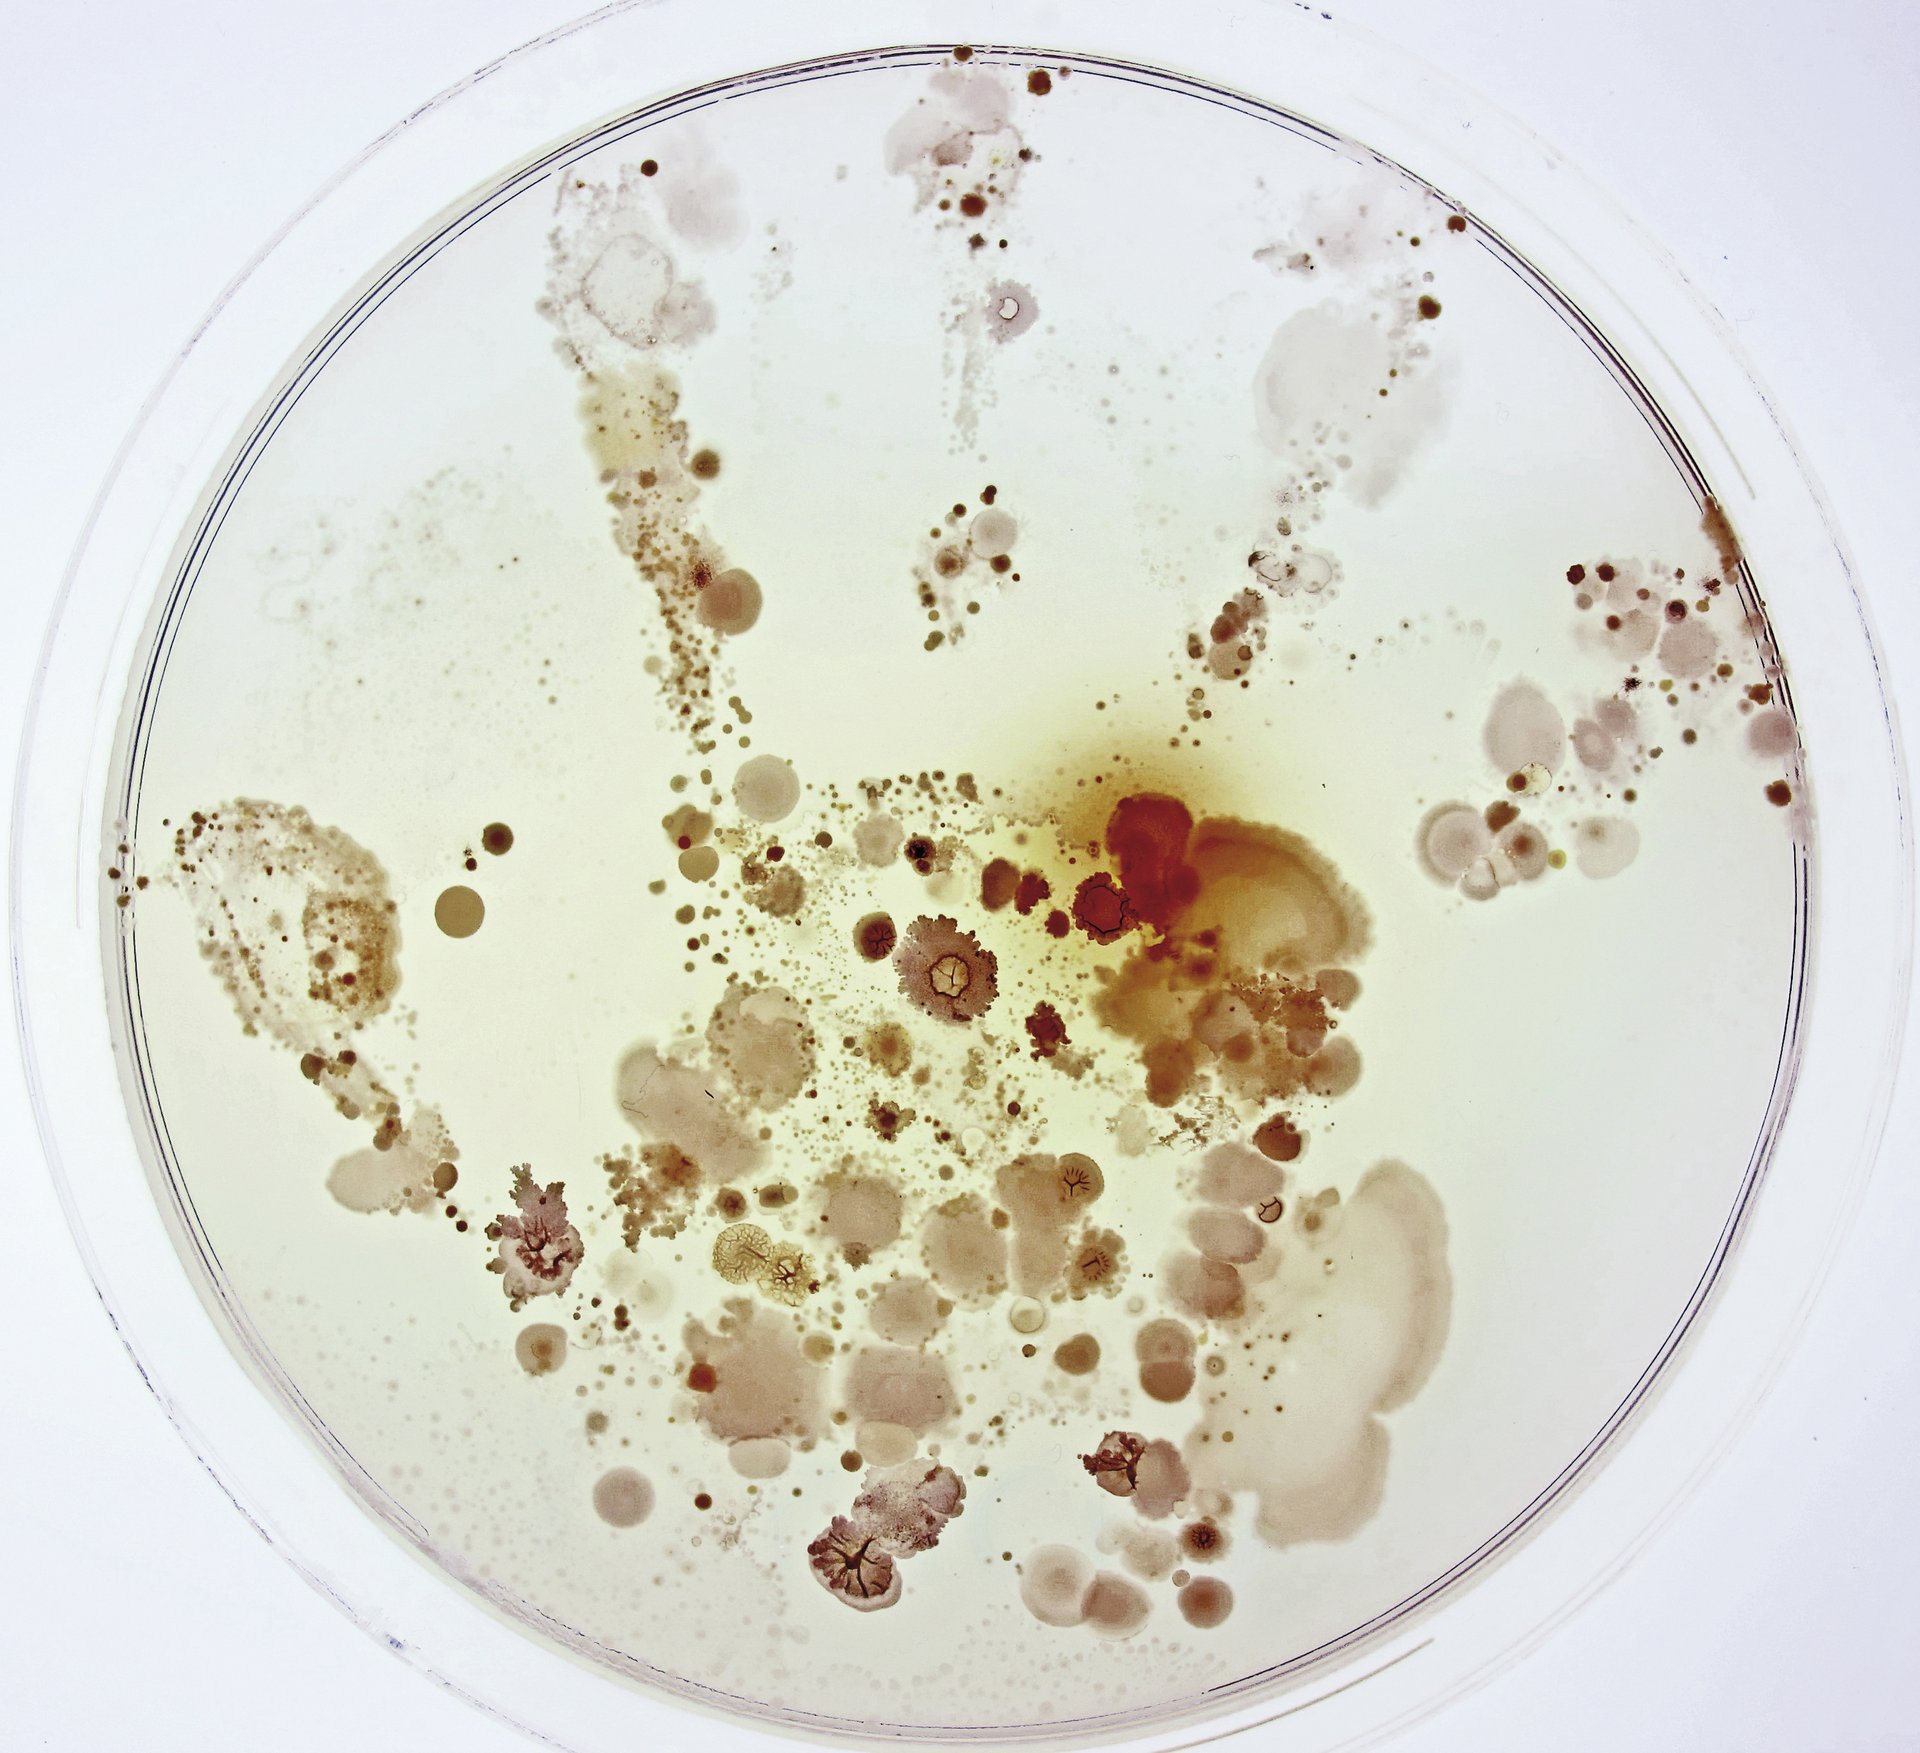
Zer dago ume baten eskuan?

Ur zikinetako surflaria
Itsas zaldia korronteetan surfean zebilen, orain adar-zati bati helduta, gero alga-zati bati… Baina, marea igotzen hasi zenean, gero eta gai artifizial gehiago agertzen hasi ziren; plastiko-zatiak, batez ere. Alga-zati bat askatu, eta plastiko-zati bati heldu zion itsas zaldiak, eta, gero, kotoi-zotz bati. Helduleku egonkorra topatu zuen.

Elkarri lotutako bizitzak
Orangutan gaztea erraz doa zuhaitzean kiribildutako pikondo igokarian gora. Behean utzi du basoa. 30 bat metro egin behar ditu, baina badaki goian pikuak aurkituko dituela. Tim Laman biologo eta argazkilariak ere hiru egun pasatu zituen zuhaitzera igo eta jaisten, goian kamerak jartzeko. Wildlife Photographer of the Year lehiaketaren 2016ko edizioko argazki onena izan zen.
Zer dago ume baten eskuan?
Sei urteko ume batek eskua Petri plaka baten gainean jarri eta bi egunez 28 ºC-an inkubatu ondoren, argazki hau atera zuten Raúl Rivas Gonzalezek eta Lorena Celador Lerak. Fotciencia lehiaketaren 13. edizioko irabazleak izan ziren.

Desertu berdetua2
Desertuaren erdian zirkulu berdeak, Saudi Arabiako Wadi As-Sirhan arroan. Kilometroko diametroa duten soroak dira, lurpeko urari esker sortuak. Ur fosila da, azken glaziazioan bete ziren lurpeko akuiferoetan dagoena. Inork ez daki zenbat dagoen.

Facebooken zer berri
Japoniako Jigokudani Monkey Park-eko turista batek gertu-gertutik atera nahi zion argazkia makako gazte honi. Bat-batean, tximinoak mugikorra kendu zion eskuetatik, eta putzu termalaren erdira alde egin zuen. Han zegoen Van Oosten, argazki bitxi hau ateratzeko prest. Wildlife Photographer of the Year 2014ko argazki sarituetako bat izan zen.

M51
Klasiko bat da astronomian, baina hau “astronomo amateur batek M51ri inoiz ateratako argazkirik ederrenetako bat da”, Astronomy Photographer of the Year 2012ko epaileen esanean.

Lizunak
Heikki Leis argazkilariak lizunekin egindako lana Elhuyar Zientzia eta Teknologiaren Hiztegi Entziklopedi-koko definizioekin elkartu genuen. Irudi honi “Bonba nuklear” izena jarri genion. Modeloa: Arbi lizundua.

Armiarmak uholdeetatik ihesi
Zuhaitzetan gora eginez egin zioten ihes milioika armiarmak 2010ean Pakistanen izandako uholdeei. Herrialde osoaren bosten bat urpean gelditu zen, eta leku batzuetan denbora luzez iraun zuen urak. Armiarmak zuhaitzetan zeuden guneetan, hainbeste urekin espero izatekoa zen baino askoz eltxo gutxiago egon zen, eta, hala, malaria zabaltzeko arriskua txikitu zuten armiarmek.

Sumendiak soja-hostoetan
-

Svalbard: bakardadea
Biodibertsitatea

Eklipseak miran
Astronomia

Sahara: bizikideak
Biodibertsitatea



